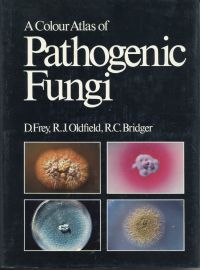

Frey, A Colour Atlas of Pathogenic Fungi.
Frey, A Colour Atlas of Pathogenic Fungi.
|
Frey, D./ Oldfield, R.J./Bridger, R.C.: A Colour Atlas of Pathogenic Fungi. London: Wolfe Medical 1979. Lex.-8°. 168 S., durchgehend Farbabbildungen, Pappband (gut erhalten)
CHF 18.00 |
Frey, A Colour Atlas of Pathogenic Fungi. (Umschlag) |
